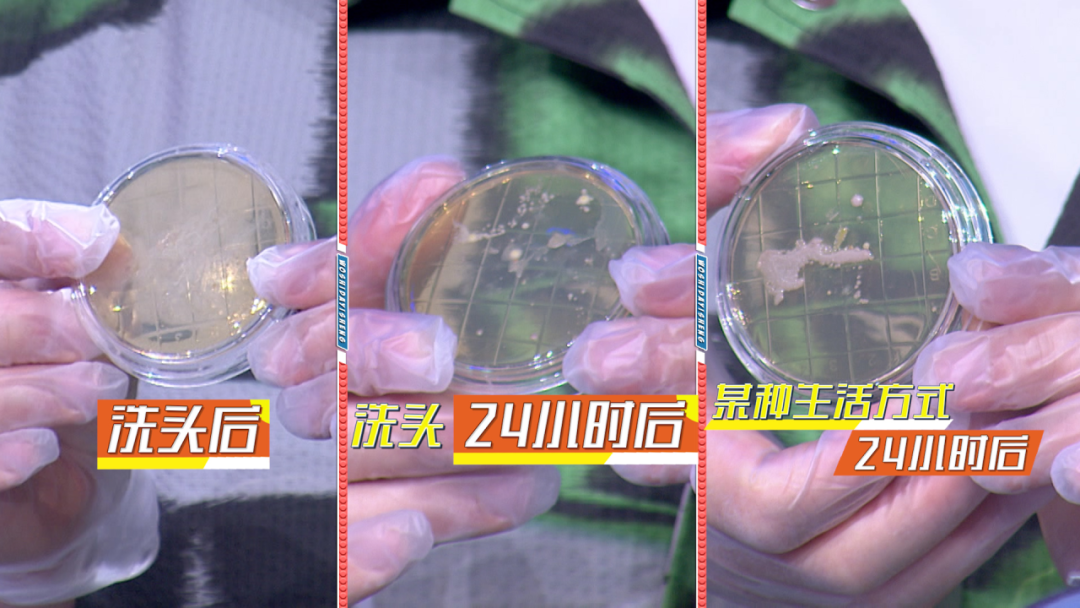
s8怎么保养【我是大医生】头皮保养 年轻的“头等”秘诀！_北京时间_https://www.jmylbn.com_新闻资讯_第8张

【我是大医生】头皮保养 年轻的“头等”秘诀!

年轻从“头”做起,乌黑亮丽的头发是年轻的标志,而养发最重要的是保养头皮。我们的头皮非常薄,是除了嘴唇和眼睑外最薄的皮肤。头皮在人体皮肤最高处,所受拉力和重力比较大,松弛下垂速度也比较快。头皮的老化速度是面部皮肤的6倍,是身体其他部位皮肤的12倍。演播室现场养发达人,现身说法告诉大家头皮保养的重要性。朱阿姨今年64岁,没有一根白发,发量和头皮健康程度比有些年轻人还要好。
《我是大医生》邀请深圳市第二人民医院廉翠红医生,为大家的头皮保养支支招。


1个动作测试你的头皮健康
头皮环境变差最直接地影响就是白发和脱发,我们可以通过拉发实验来自测一下是否已经存在了脱发。在三天未洗头的情况下,用三根手指捏住一缕头发,拉直从发根捋到发梢。如果被拉掉的头发有5到6根,就说明急需保养头皮了。

2个常见的生活习惯损伤头皮
近日,宁波65岁的胡女士每年染发两次,十年后确诊癌症的新闻登上了热搜。很多人认为白发染黑就可以显得年轻,实则暗藏危机。哈佛大学的研究人员对12万名女护士进行了一项长达36年的调查,这项研究和结果发表在英国医学杂志上,经常烫发、染发的女性患癌风险会增加30%~45%。染发剂中的固色成分苯二胺也被世卫组织癌症研究机构纳入了致癌物的行列。因此建议大家坚持正确的头皮保养,切勿频繁染发。


另外一个常见的生活习惯几乎每个人都做过,就是戴帽子。戴帽子导致我们头皮真菌肆意横生。因此选择透气性好的帽子,佩戴时长不超过3小时,尤其在头发出油的阶段反而更不推荐戴帽子,出油出汗给细菌真菌提供了良好的繁殖环境,损伤我们的头皮。

2招保养秘诀让头皮“返老还童”
第一招就是梳头,梳子的选择以及梳头的时间很有讲究。有些塑料材质的梳子梳头时容易产生静电,不仅使头皮沾染了灰尘,还会损伤我们的发质,让头发变得毛糙。专家推荐牛角梳和有气垫的圆头梳,并且梳头时间每天坚持10分钟,达到头皮按摩的作用,促进头皮微循环。




另一招我们可以选择一些头皮保养的精华液,像面部护理一样涂抹在头皮上,保持头皮的水油平衡。节目中将揭晓哪些营养成分有利于头皮保养。


还有哪些小自测可以帮助我们了解自己的头皮状态?4月11日北京卫视21:15和《我是大医生》一起保养好头皮,开启健康新生活吧!